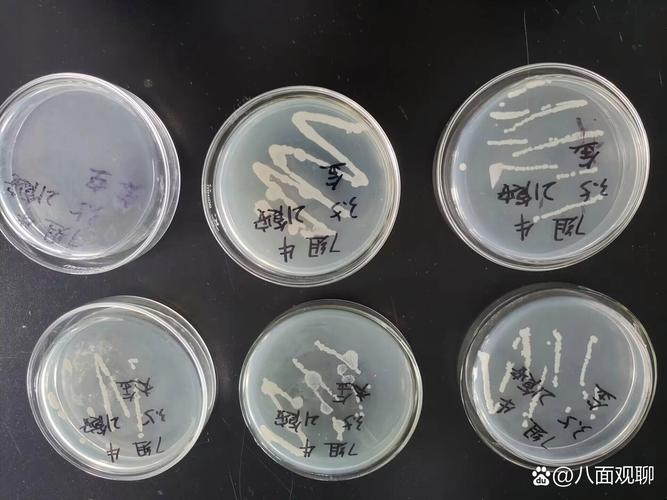
生物絮团技术如何高效培养目标菌类？-图3

生物絮团技术菌类培养是水产养殖中一项重要的生态调控手段,通过定向培养复合微生物群落,形成具有净化水质、提供饵料等多功能作用的絮凝体,从而实现养殖系统的生态平衡和高效生产,该技术的核心在于菌类的筛选、培养及群落构建,其科学性和系统性直接决定了技术应用效果。

生物絮团技术中菌类培养的原理与意义
生物絮团的形成本质上是微生物在特定环境条件下,通过分泌胞外聚合物(EPS)将自身、有机碎屑、无机颗粒等包裹聚集形成的颗粒状聚集体,菌类作为絮团的核心组分,其群落结构和功能多样性决定了絮团的稳定性与效能,在水产养殖系统中,氨氮、亚硝酸盐氮等氮废物积累是制约产量的主要因素,而菌类通过硝化作用(将氨氮转化为亚硝酸盐氮,再转化为硝酸盐氮)、反硝化作用(将硝酸盐氮转化为氮气)以及异养菌对有机物的分解作用,能够有效降低水体中有害物质浓度,絮团中的光合细菌、乳酸菌等还能产生抑菌物质,抑制病原菌生长,同时絮体本身可作为滤食性水产动物的优质饵料,补充营养。
菌类培养的核心目标是通过调控环境参数(如碳氮比、溶解氧、pH等),促进有益菌(如硝化细菌、芽孢杆菌、酵母菌等)的快速增殖,并抑制有害菌(如弧菌等)的生长,形成以有益菌为主导的稳定微生物群落,这一过程不仅依赖于菌种的自身特性,更需要养殖环境的协同作用,因此菌类培养是生物絮团技术成功应用的关键环节。
菌类培养的核心菌种及其功能
生物絮团中的菌类种类繁多,根据其代谢功能和作用,可分为以下几类:
| 菌类类型 | 代表菌种 | 主要功能 |
|---|---|---|
| 硝化细菌 | 亚硝化单胞菌、硝化杆菌 | 将氨氮转化为亚硝酸盐氮,再转化为硝酸盐氮,降低水体毒性。 |
| 反硝化细菌 | 假单胞菌、反硝化杆菌 | 在缺氧条件下将硝酸盐氮转化为氮气,去除水体中的总氮。 |
| 有机分解菌 | 枯草芽孢杆菌、地衣芽孢杆菌 | 分解水体中的有机碎屑、残饵、粪便等,减少有机污染,为其他菌类提供碳源。 |
| 光合细菌 | 红螺菌、类球红细菌 | 利用光能分解硫化氢、氨氮等有害物质,同时提供单细胞蛋白作为饵料。 |
| 乳酸菌 | 乳酸杆菌、乳酸球菌 | 产生乳酸等有机酸,降低pH,抑制病原菌生长,调节肠道菌群。 |
| 酵母菌 | 酿酒酵母、产朊假丝酵母 | 分解有机物,产生B族维生素和酶类,促进动物消化吸收,增强免疫力。 |
这些菌种并非单独作用,而是通过协同代谢形成复杂的微生物生态系统,有机分解菌将大分子有机物分解为小分子物质,为硝化细菌和反硝化细菌提供碳源和能源;光合细菌则通过光合作用补充水体溶解氧,同时降解硫化物等有毒物质,为好氧菌创造适宜环境。

菌类培养的关键技术环节
菌种筛选与复合菌剂构建
菌种筛选是生物絮团技术的基础,需根据养殖对象、水质条件和目标功能选择适宜菌种,筛选标准包括:生长速度快、环境适应性强(如耐高盐、耐pH波动)、代谢活性高(如硝化速率、有机物降解能力)、安全性(无致病性),实际应用中通常采用复合菌剂,通过不同菌种的协同作用增强絮团功能,将芽孢杆菌(有机分解能力强)与硝化细菌(氮转化高效)复合,可同时解决有机污染和氨氮积累问题;添加光合细菌则能提升絮团的抗逆性和饵料价值。
培养基与碳氮比调控
培养基是菌类生长的营养基础,需提供充足的碳源、氮源、无机盐和生长因子,生物絮团培养中,碳源是关键限制因子,因为养殖水体中氮废物(氨氮、亚硝酸盐氮)丰富,而碳源(如葡萄糖、淀粉、糖蜜、甲醇等)相对不足,适宜的碳氮比(C/N)是絮团形成和功能发挥的核心参数,一般推荐C/N为10-15:1(质量比),碳氮比过低会导致硝化细菌竞争不过异养菌,氨氮去除效率下降;碳氮比过高则会造成有机物残留,增加水体负担,实际生产中常用糖蜜、淀粉等廉价碳源,通过计算水体中总氮含量,按比例添加碳源,并实时监测水质变化动态调整。
环境条件控制
菌类生长对环境条件敏感,需严格控制以下参数:
- 溶解氧(DO):好氧菌(如硝化细菌、芽孢杆菌)是絮团的优势菌群,需维持DO在5-8 mg/L;反硝化细菌则在缺氧条件(DO<1 mg/L)下发挥作用,因此可通过曝气强度和时间调控絮团内部的微氧环境。
- pH:大多数菌类适宜pH为7.0-8.5,可通过添加碳酸氢钠或石灰调节,避免pH波动过大。
- 温度:一般菌类适宜生长温度为20-35℃,过高或过低会抑制代谢活性,需根据季节调整培养策略。
- 盐度:不同菌种对盐度耐受性不同,海水养殖需选择耐盐菌种(如海洋芽孢杆菌),淡水养殖则可选用淡水菌种。
絮体形成与调控
絮体形成是菌类培养的直观结果,需通过搅拌、曝气等方式提供剪切力,促进微生物聚集,絮体大小需控制在适宜范围(通常为0.2-2.0 mm),过小则沉降性差,易被水流冲走;过大则比表面积小,微生物活性低,可通过调节搅拌强度、接种量、碳源种类等参数控制絮体粒径,絮体的沉降性能是衡量絮团稳定性的重要指标,良好的沉降性有助于实现固液分离,减少水体悬浮物。
菌类培养的挑战与优化方向
尽管生物絮团技术具有显著优势,但在菌类培养过程中仍面临挑战:一是菌种稳定性问题,长期培养后优势菌种可能被淘汰,导致絮团功能退化;二是环境波动(如水质突变、温度骤变)对微生物群落的冲击;三是碳源成本较高,影响技术推广,针对这些问题,可通过以下途径优化:
- 固定化微生物技术:将菌包埋于载体(如活性炭、海藻酸钠)中,提高菌种存活率和抗逆性;
- 基因工程改造:构建高效工程菌,增强特定代谢功能(如高活性硝化细菌);
- 智能调控系统:利用在线传感器实时监测水质参数,通过算法自动调控碳源添加、曝气强度等,实现精准培养;
- 廉价碳源开发:利用农业废弃物(如秸秆、木薯渣)发酵制备碳源,降低生产成本。
相关问答FAQs
Q1:生物絮团技术中,如何判断菌类培养是否成功?
A:判断菌类培养是否成功主要通过以下指标综合评估:①絮体形态:形成肉眼可见的淡黄色或褐色絮状物,大小均匀,沉降性好;②水质指标:氨氮、亚硝酸盐氮浓度显著下降(通常24小时内去除率≥50%),COD降低,pH稳定在7.0-8.5;③微生物活性:显微镜下观察到大量细菌、原生动物等,菌群多样性高,无致病菌(如弧菌)大量繁殖;④养殖效果:养殖动物生长速度加快,发病率降低,饵料系数下降。
Q2:生物絮团培养过程中,如何防止有害菌(如弧菌)污染?
A:防止有害菌污染需采取综合防控措施:①菌种把关:选用经过安全性验证的商业菌剂或实验室分离的有益菌,避免引入外源病原菌;②环境调控:维持较高的溶解氧(>5 mg/L)和适宜的pH(7.5-8.5),抑制弧菌(厌氧或微氧菌)生长;③碳源优化:选择易被有益菌利用的碳源(如糖蜜、葡萄糖),避免碳源过剩导致腐败菌滋生;④定期监测:通过平板计数或分子生物学方法(如PCR)检测菌群结构,发现弧菌超标时及时增加有益菌投放量或使用消毒剂(如过硫酸氢钾)处理;⑤生态竞争:保持絮团中异养菌和硝化细菌的优势地位,通过竞争抑制弧菌繁殖。
